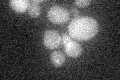
YJL100W
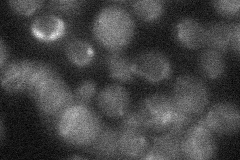
YJL100W

View description
Type II phosphatidylinositol 4-kinase that binds Las17p, which is a homolog of human Wiskott-Aldrich Syndrome protein involved in actin patch assembly and actin polymerization
Localization:
Intensity:
Fold change:
Significance:
-
C’ GFP library in SD
below threshold15.91 -
N' NOP1pr-GFP in SD

vacuole membrane61.57 -
N' TEF2pr-mCherry in SD

vacuole membrane59.6617 -
N' NATIVEpr-GFP in SD
below threshold20.1923 -
N' TEF2pr-VC and Cyto-VN in SD

vacuole membrane39.8907 -
C’ GFP library in SD+DTT

cytosol16.891.06No -
C’ GFP library in SD+H2O2

cytosol17.941.12No -
C’ GFP library in Starvation Media

cytosol13.890.87No -
C’ GFP library on the background of Pup2-DaMP

below threshold -
C’ GFP library on the background of CCT mutant

below threshold17.5571.10314No
